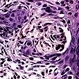

-
 By Lancaster Course in Ophthalmology
By Lancaster Course in Ophthalmology
1980 - Uploaded on Feb 25, 2019.
- Last modified by Caroline Bozell on Feb 28, 2019.
- Rating
- Appears in
- Unit 05 Diseases of the Eyelids
- Condition/keywords
- junctional nevus, epidermis
- Description
- One nest of junctional nevus cells at the base of the epidermis and larger nodules of nevus cells in the dermis make this a "compound" nevus.


 Initializing download.
Initializing download.